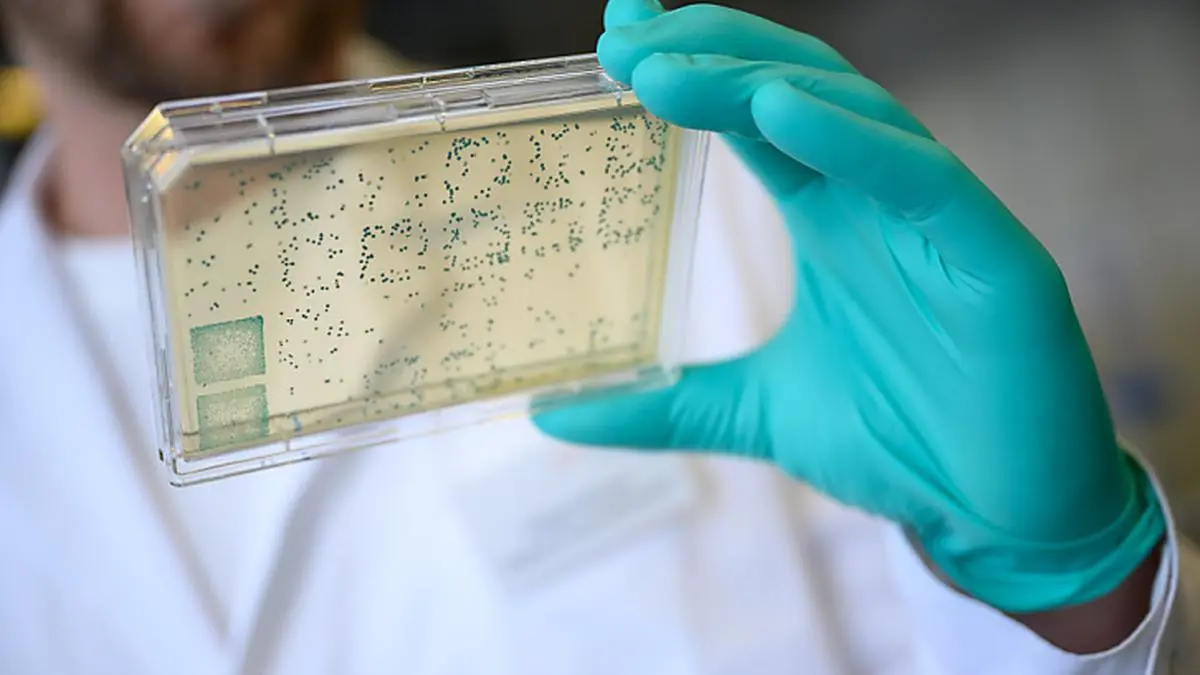

APA
Erster bestätigter Coronavirus-Fall in Wien
In Wien gibt es einen ersten bestätigten Fall einer Infektion mit dem neuartigen Coronavirus. Das gab das Büro von Gesundheitsstadtrat Peter Hacker (SPÖ) der APA bekannt. Betroffen sei ein 72-jähriger Mann. Er befindet sich in der Isolierabteilung des Krankenhauses Rudolfstiftung in der Landstraße. Nähere Details zu dem Fall wurden vorerst nicht genannt.
© APA (Symbolbild/dpa)